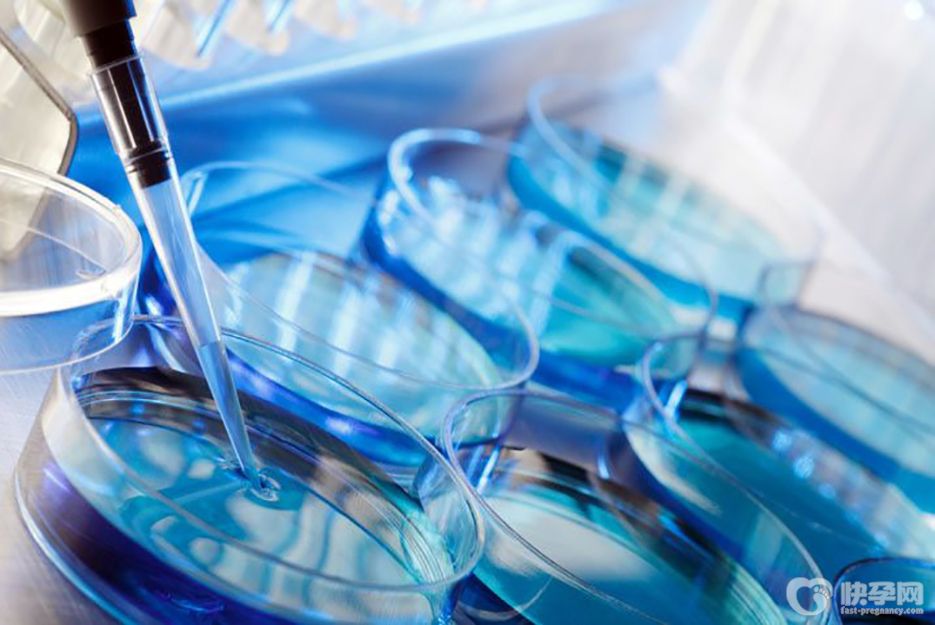

供精做试管婴儿的全部流程解读,一共分为八个步骤!
- 试管婴儿
- 2024-11-03 11:17
供精试管婴儿就是使用存于人类精子库的精子使女方受孕,适用于男性原发性无精症和继发性无精症,或者患有染色体方面疾病,无法生育健康后代的男性。做供精试管婴儿为了成功率一般都会选择技术好的医院,因此很多患者都是从外地远道而来,因此提前了解流程很重要。今天为大家详细解读供精做试管婴儿的全部流程,一共分为八个步骤。
供精试管的全部流程:
1、申请建立档案
如果大家想要做试管婴儿,首先就需要到专业的生殖中心去申请和建立档案,这样才能根据情况筛选供精资源。
2、检查身体
因为做供精试管婴儿主要是和女性有直接刮板西,所以在这之前女性朋友需要进行全面的身体检查,以确保女性朋友的身体状态适合做试管婴儿。
3、促排卵
在一切准备就绪,供精资源也选择好之后,女性朋友就需要进行促排卵治疗了,会根据女性朋友的身体状态选择合适的促排卵方案实现超常规排卵。
4、监测排卵
在使用促排卵药物期间,女性朋友要按照医生的建议到已经进行排卵监测,主要是通过B超检查,对卵泡的发育情况进行了解,以便安排取卵时间。
5、取卵
在卵泡发育至18毫米左右就需要安排取卵了,否则很容易出现自行排卵的情况,这时候多采取无痛取卵方式,将发育成熟的卵子取出来。
6、受精培育
将取出来的卵子进行优化处理后开始受精,并且将成功受精的受精卵进行储配培育,让其发展为胚胎。
7、胚胎移植
移植的方案不一样,移植的时间也不一样,大家根据医生的建议在合适的时间内到医院接受移植即可。
8、确认妊娠
在完成以后后的第14天就可以进行确认妊娠检查了,不管是否成功怀孕,整个供精试管婴儿的过程都结束了。总之,在整个供精试管婴儿过程中大家都需要积极配合,保持一个积极乐观的心态,这对保障试管婴儿的成功率是非常重要的。
总结:以上就是对对供精试管婴儿全程流程,一般在丈夫能提供健康精子的情况下都是不建议做供精试管婴儿的,毕竟这种助孕方案涉及到了第三个人,所出生的孩子和父亲不具有血缘关系,所以有的家庭可能会难以接受,务必要考虑清楚后再决定。如果大家确实存在生育难题,可以选择去专业医院咨询和了解,选择一种适合自身情况的助孕方案来实现自己的生育愿望。

发表评论